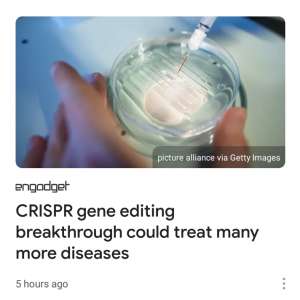
Image

Melania Tweets For First Time Since Memorial Day With July 4th Message - Red Paper News
Former First Lady Melania Trump tweeted for the first time since Memorial Day with a July 4th message. “Wishing everyone a safe and happy Independence Day!” Melania wrote.
https://www.redpapernews.com/melania-tweets-for-first-time-since-memorial-day-with-july-4th-message/Notice: Undefined index: tg1tga_access in /home/admin/www/anonup.com/themes/default/apps/timeline/post.phtml on line 396
Notice: Undefined index: tg1tga_access in /home/admin/www/anonup.com/themes/default/apps/timeline/post.phtml on line 396
Notice: Undefined index: tg1tga_access in /home/admin/www/anonup.com/themes/default/apps/timeline/post.phtml on line 396

BREAKING: 93 ARRESTS Made In "Operation 614"- This Is One Of The Biggest Busts In THIS States History
SICK! In total, 53 victims were identified and referred to services and 93 arrests were made.
https://americasfreedomfighters.com/breaking-93-arrests-made-in-operation-614-this-is-one-of-the-biggest-busts-in-this-states-history/Notice: Undefined index: tg1tga_access in /home/admin/www/anonup.com/themes/default/apps/timeline/post.phtml on line 396
Notice: Undefined index: tg1tga_access in /home/admin/www/anonup.com/themes/default/apps/timeline/post.phtml on line 396
Notice: Undefined index: tg1tga_access in /home/admin/www/anonup.com/themes/default/apps/timeline/post.phtml on line 396
Notice: Undefined index: tg1tga_access in /home/admin/www/anonup.com/themes/default/apps/timeline/post.phtml on line 396
Notice: Undefined index: tg1tga_access in /home/admin/www/anonup.com/themes/default/apps/timeline/post.phtml on line 396
Notice: Undefined index: tg1tga_access in /home/admin/www/anonup.com/themes/default/apps/timeline/post.phtml on line 396
Only followers of this user (OhioKimberly) can see their posts
Notice: Undefined index: tg1tga_access in /home/admin/www/anonup.com/themes/default/apps/timeline/post.phtml on line 396
Notice: Undefined index: tg1tga_access in /home/admin/www/anonup.com/themes/default/apps/timeline/post.phtml on line 396
Notice: Undefined index: tg1tga_access in /home/admin/www/anonup.com/themes/default/apps/timeline/post.phtml on line 396
What if no one else stands up?
Nana can tell you what will happen we will loose our country and planet forever!
There is NO FOOKN 2022 OR 2024 if we dont correct the fraud of the 2020 election!
Watch "The Deep Rig" movie today!
Drop what your are doing and watch it!
wainthepain01
@doqholliday
@jfkjrfan
@genflynn
@danuscg
https://thedeeprig.movie/

The Deep Rig - Documentary
Ask the questions that censorship-happy mainstream media doesn’t want you to ask. Reveal the truth that Twitter sacrificed millions of accounts to hide. Follow the team of lawyers & ‘cyber ninjas’, determined to reveal the facts behind the headlines, to backroom scenes and through electronic netwo..
https://thedeeprig.movie/Notice: Undefined index: tg1tga_access in /home/admin/www/anonup.com/themes/default/apps/timeline/post.phtml on line 396
Notice: Undefined index: tg1tga_access in /home/admin/www/anonup.com/themes/default/apps/timeline/post.phtml on line 396
Notice: Undefined index: tg1tga_access in /home/admin/www/anonup.com/themes/default/apps/timeline/post.phtml on line 396
Notice: Undefined index: tg1tga_access in /home/admin/www/anonup.com/themes/default/apps/timeline/post.phtml on line 396
Notice: Undefined index: tg1tga_access in /home/admin/www/anonup.com/themes/default/apps/timeline/post.phtml on line 396
TexasVet
3h
"Governor Greg Abbott of Texas has asked for assistance from other states to help protect our southern border until us Texans can finish building the wall ourselves. Florida Governor Ron DeSantis announced that he is sending law enforcement personnel to do so. Together we will hold back the hordes of Mordor! "
#SAVEAMERICA
Notice: Undefined index: tg1tga_access in /home/admin/www/anonup.com/themes/default/apps/timeline/post.phtml on line 396
https://www.bitchute.com/v...
#MyBalconyGardenNEWS
Notice: Undefined index: tg1tga_access in /home/admin/www/anonup.com/themes/default/apps/timeline/post.phtml on line 396
Many will try to scare you and keep you in low frequency, that is their game to keep your mind on bad things happening instead of manifesting good things and a wonderful new future.
Prepare for your family on supplies for a few weeks just in case they have their last false flag attempt. You are aware that they plan something big and scary. KNOW that the military have our backs, but more importantly God has us no matter what happens.
DONT ALLOW THEIR FEAR TO RULE YOUR DAY!
TALK ABOUT IT, SHARE IT BUT DONT LET IT STICK TO YOU!
Notice: Undefined index: tg1tga_access in /home/admin/www/anonup.com/themes/default/apps/timeline/post.phtml on line 396
Documentary-10 part series by award-winning researcher Janet Ossebaard.
A great red pill for those looking for truth and a crash course in #QANON & The #GREATAWAKENING
https://greatawakeningrepo...
#MyBalconyGardenNEWS
Notice: Undefined index: tg1tga_access in /home/admin/www/anonup.com/themes/default/apps/timeline/post.phtml on line 396
Only followers of this user (MidnightRyder) can see their posts
#sayit #USA #America #Amerika #Trump #Germany #HoldTheLine #Deutschland
Notice: Undefined index: tg1tga_access in /home/admin/www/anonup.com/themes/default/apps/timeline/post.phtml on line 396
Notice: Undefined index: tg1tga_access in /home/admin/www/anonup.com/themes/default/apps/timeline/post.phtml on line 396
Notice: Undefined index: tg1tga_access in /home/admin/www/anonup.com/themes/default/apps/timeline/post.phtml on line 396
By Michael Baxter - May 15, 2021
Donald J. Trump and the U.S. military have expressed unease over Dr. Anthony Fauci’s recent real estate acquisitions in the United Kingdom, Argentina, and Panama, heightening concerns that the Deep State doctor might flee the country ahead of being served an arrest warrant for crimes committed against America and its people. ...
https://realrawnews.com/20...
Notice: Undefined index: tg1tga_access in /home/admin/www/anonup.com/themes/default/apps/timeline/post.phtml on line 396
Notice: Undefined index: tg1tga_access in /home/admin/www/anonup.com/themes/default/apps/timeline/post.phtml on line 396
Listen please for your own good if your thinking if taking vaxx
Notice: Undefined index: tg1tga_access in /home/admin/www/anonup.com/themes/default/apps/timeline/post.phtml on line 396
WEF sponsored Event 201 which did pandemic planning 2 months before COVID.
They also helped coordinate response to COVID.
And they plan the "Great Reset" - "Build Back Better".
https://threadreaderapp.co...
Notice: Undefined index: tg1tga_access in /home/admin/www/anonup.com/themes/default/apps/timeline/post.phtml on line 396